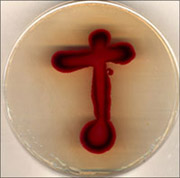

Critical Art Ensemble
Germs of Deception
Als die ersten Anthrax-Briefe nach dem 11.9.2001 in Umlauf kamen,
eröffnete sich ein neues Horrorszenario: Terroristen, die biologische
Waffen einsetzen. Bakterien, die nicht wahrnehmbar in unseren Organismus
eindringen. Unsichtbare Kriegsführung.
Seitdem setzt sich eine neue Maschinerie der Untersuchung und Abwehr
in Bewegung. Neue Fonds für Forschung und Forschungszentren,
Verträge für Materialien wie Impfstoffe und symptomverhaftete
Medikamente, Sicherheitsverträge und vieles mehr überschwemmen
den Markt in einem solchen Ausmaß, dass fast jeder Produktions-
und Dienstleistungsapparat ein Interesse daran hat, das Schauspiel
von Angst und Bedrohung andauern zu lassen. Ob eine wirkliche Bedrohung
existiert oder nicht, ist nicht relevant für dieses Netzwerk.
Mit der Frage, wie real die Bedrohung durch biologische Waffen tatsächlich
ist, bzw. wem ein solches Szenario der Bedrohung dienlich sein könnte,
beschäftigt sich das aktuelle Projekt des Critical Art Ensemble.
Einer der Initiatoren, Steve Kurtz, wird wegen dieses Kunstprojektes,
in dessen Rahmen auch mit Bakterien gearbeitet wird, seit 2004 in
den USA strafrechtlich verfolgt. Der zunächst erhobene Vorwurf
des Bio-Terrorismus konnte nicht aufrecht erhalten werden. Die Bundesstaatsanwaltschaft
versucht jedoch weiterhin eine Sicherheits- und Gesundheitsangelegenheit
aus dem Fall zu machen und verfolgt die Weitergabe der Bakterien
juristisch als "mail fraud". Dennoch bleibt der Überwachungsapparat
aktiv.
read more
 CAE: Körper
der Angst in einer Welt der Bedrohung (PDF) CAE: Körper
der Angst in einer Welt der Bedrohung (PDF)
 CAE: Nutzlose
Wetware und wahnsinnige Strategien (PDF) CAE: Nutzlose
Wetware und wahnsinnige Strategien (PDF)
 http://www.critical-art.net http://www.critical-art.net
 http://www.caedefensefund.org http://www.caedefensefund.org
Critical Art Ensemble (CAE) ist ein
Kollektiv taktischer Medienaktivisten mit unterschiedlichem Hintergrund
(Computergraphik und Webdesign, Biotechnologie, Film/Video, Fotografie,
Text-, Buch- und Perfomance-Kunst). Gegründet 1987, konzentriert
sich das CAE auf die Untersuchung der Überschneidungen zwischen
Kunst, kritischer Theorie, Technologie und politischem Aktivismus.
Das Kollektiv hat eine breite Vielfalt an Projekten für ein
internationales Publikum produziert und an so unterschiedlichen
Orten wie der Straße, dem Museum oder dem Internet aufgeführt.
Das Critical Art Ensemble hat bislang fünf Bücher veröffentlicht:
The Electronic Disturbance, und die Fortführung: Electronic
Civil Disobedience and Other Unpopular Ideas; Flesh Machine: Cyborgs,
Designer Babies, and New Eugenic Consciousness und die Fortführung:
The Molecular Invasion; sowie Digital Resistance: Explorations in
Tactical Media.
Critical Art Ensemble (CAE) is a collective
of tactical media practitioners of various specializations, including
computer graphics and web design, wetware, film/video, photography,
text art, book art, and performance. Formed in 1987, CAE's focus
has been on the exploration of the intersections between art, critical
theory, technology, and political activism. The collective has performed
and produced a wide variety of projects for an international audience
at diverse venues ranging from the street, to the museum, to the
Internet. Critical Art Ensemble has also written five books: The
Electronic Disturbance, and its companion text, Electronic Civil
Disobedience and Other Unpopular Ideas; Flesh Machine: Cyborgs,
Designer Babies, and New Eugenic Consciousness and its companion
text, The Molecular Invasion; and Digital Resistance: Explorations
in Tactical Media.
|

|



